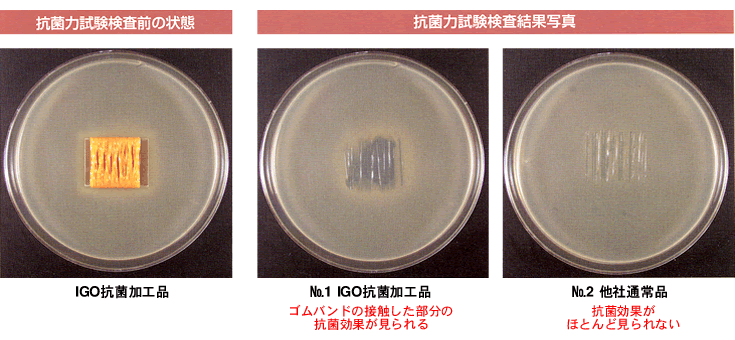
抗菌力試験検査結果写真

- 輪ゴムの専門店 ライサネット
※ ● 重要なお知らせ ● ※ - 平素は弊社(ライサ株式会社)をご利用いただき、誠にありがとうございます。
最近、弊社の名前をかたった偽サイトが存在し、詐欺行為が報告されています。
弊社取扱商品以外の販売等も見受けられますが弊社とは一切関係ございません。
偽サイトでは商品を購入したにもかかわらず商品が届かないという被害が発生しています。
皆様におかれましては充分にご注意いただきますようお願い申し上げます。


IGO製のゴムバンドは、お客様に、より安心して、より安全にゴムバンドを使用頂くために、ゴムバンドに抗菌加工を施しております。
ゴムバンドを使用する局面としては、食品包装(持ち帰り弁当・惣菜)及び、農業出荷資材(野菜の結束等)に主に使用されており、昨今、衛生面においてより安全性が問われる時代になってきております。
特に野菜の結束においては、ゴムバンドが“直接”野菜に触れるため、抗菌加工はより有効と考えております。
ゴムバンドは元来、ある程度の抗菌効果を持っておりますが、抗菌加工を施す事により安全性が高まるものと確信しております。
又、使用する抗菌剤においても、銀イオン系のものでなく、食品添加物にも使用されている、口に入れても安全な有機系の抗菌剤を使用しております。

1.検体名:No.1 IGOゴムバンド抗菌加工品(#16)
No.2 IGO他社ゴムバンド通常品(#16)
2.検査目的:抗菌試験(ハローテスト)
3.試験方法:JlS L1902:2002(八ロー法)を参考に実施した。
- 1) 供試菌株:Staphylococcus aureus IFO 12732(黄色ブドウ球菌)
- 2) 試験試料:ガラス板に約2.5×2.5cmの大きさになるよう、各々の検体ゴムバンドを7本づつ巻き付け、試験試料とした。
- 3) 試験用平板培地:普通ブイヨンで培養した供試菌液を、普通寒天培地1ml当たり100000cfuとなるように希釈接種し、滅菌シャーレ(径9cm)に15mlずつ分注、固化させたものを試験用平板培地とした。
- 4) 試験操作:上記2)の各試験試料を、上記3)の試験用平板培地の中央に密着させたのち、35℃48時間培養し、供試菌に対する発育阻止帯の有無を観察した。


1kg・500gの袋にUVカット素材を使用しております。 ゴムバンドの劣化の最大の要因は紫外線(主に太陽光の中に含まれる)であり、その紫外線をできる限りカットする事で、よりゴムバンドを長持ちさせる事ができる様になりました。

